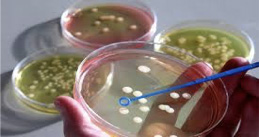

di Pietro Cernigliaro
Presidente ANDMI
Il 17 novembre 2016, l’Accademia dei Georgofili ha ospitato Mipaaf (Ministero delle Politiche Agricole), Crea (Consiglio per la ricerca in agricoltura e l’analisi dell’economia) e Clan (Cluster tecnologico agrifood nazionale), per presentare l’innovazione nell’agroalimentare italiano nei prossimi tre anni, tra biotecnologie sostenibili e agricoltura di precisione.
L’evento si è incentrato attorno ad alcuni temi tra i quali in particolare quelli relativi alla individuazione delle opportunità che il progresso tecnologico offre al sistema agroalimentare italiano e soprattutto quali cambiamenti ci aspettano.
Crea è impegnata nel prossimo futuro a sviluppare progetti sulla biotecnologia, sull’agricoltura digitale, sulla creazione di aziende agricole dove si possano mettere a frutto le ricerche che permettano di ridurre i tempi di sviluppo di nuove varietà senza ricorso a Ogm, a tutela della biodiversità italiana; in buona sostanza si è sostenuta l’esigenza di fare ripartire la ricerca fruendo dei fondi messi a disposizione dal Mipaaf.
Le proposte del Clan si proiettano in particolare verso la salute e benessere, sicurezza alimentare, migliore qualità degli alimenti, potenziamento della produzione sostenibile, tracciabilità e rapporto trasparente con i consumatori
Il Ministro del Mipaaf, Martina ha concluso il convegno affermando la sua grande attenzione per la ricerca, l’assistenza in campo agricolo, la biodiversità e l’agricoltura digitale indispensabili per aumentare la competitività dell’agricoltura italiana.
Fonte AgroNotizie
Riproduzione riservata
Copyright 2016

